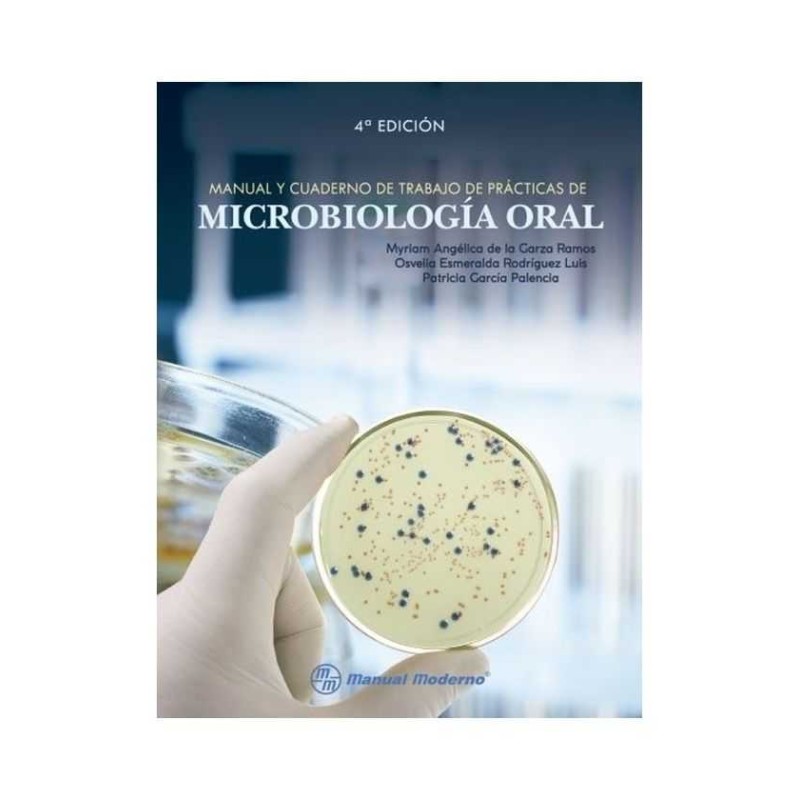
Manual y Cuaderno de Trabajo de Prácticas de Microbiología Oral
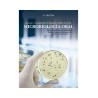
Manual y Cuaderno de Trabajo de Prácticas de Microbiología Oral

El Manual y cuaderno de trabajo de prácticas de microbiología oral, 4ª edición, tiene como objetivo el que los estudiantes de odontología y de otras ciencias de la salud conozcan las generalidades micro y macroscópicas de los principales microorganismos relacionados con la práctica clínica, y cuya intención es mejorar en la práctica clínica.
Esta obra se compone de numerosas imágenes que describen los principales materiales y procedimientos que forman parte de la práctica cotidiana en el laboratorio de microbiología. Asimismo, hay una serie de prácticas y ejercicios para trabajar de manera didáctica el contenido del libro.
El Manual y cuaderno de trabajo de prácticas de microbiología oral, 4ª edición, es un libro que retoma los fundamentos, estrategias y recomendaciones para cualquier interesado en el área de ciencias de la salud.